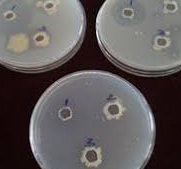
ODC-50

Zinc is one of the imperative micronutrients required relatively in small
1
concentrations (5–100 mg kg ) in tissues for healthy growth and reproduction
of plants. Zinc deciency in plants leads to reduced membrane integrity and synthesis of carbohydrates, auxins,
nucleotides, cytochromes, and chlorophyll and develops susceptibility to heat stress.Application of inorganic zinc
partially caters the plant need as 96–99% of applied Zn is converted into different insoluble forms within 7 days of
application ((ZnO and ZnCO etc ). Microbes are potential alternate that could cater plant zinc requirement by solubilising 3 .
the complex zinc in soil.
Zinc is one of the imperative micronutrients required relatively in small
1
concentrations (5–100 mg kg ) in tissues for healthy growth and reproduction
of plants. Zinc deciency in plants leads to reduced membrane integrity and synthesis of carbohydrates, auxins,
nucleotides, cytochromes, and chlorophyll and develops susceptibility to heat stress.Application of inorganic zinc
partially caters the plant need as 96–99% of applied Zn is converted into different insoluble forms within 7 days of
application ((ZnO and ZnCO etc ). Microbes are potential alternate that could cater plant zinc requirement by solubilising 3 .
the complex zinc in soil.
| TALC BASED BIOFERTILIZER |
|---|
| SEED TREATMENT : Mix 200-250gm BIO-ZINC in 300 ml water containing 5% Jaggery/ Gur as adhesive to make slurry. Add the slurry to seed an acre of land and mix. Dry the treated seeds in shade and sow in eld as soon as possible. Dried seeds should not be stored for long. |
| SEED PELLETING : BIO-ZINC coated seeds are sprinkled with powdered neem cake or neem leaf powder mix with hands before sowing. Seeds can also be coated with 2-3% of calcium carbonate if soils are acidic in nature |
| SOIL APPLICATION :1kg BIO-ZINC in 50kg of organic manure. Spread this mixture evenly in 1 acre elds |
| SOIL BROADCASTING : Mix 1.5kg BIO-ZINC with 50kg of cow dung. Add water to make the mixture damp and cover it with a porous gunny bag. Mixing should be done in shade. After 12 hours broadcast the mixture over 1 acre [0.4 ha] |
| APPLICATION THROUGH IRRIGATION : |
| LIQUID BIOFERTILIZER |
|---|
| SEED TREATMENT : Mix 50-100ml BIO-ZINC in clean water containing 5% Jaggery/Gur/ CMC as adhesive. Add the solution to seeds of an acre of land and mix. Dry the treated seeds in shade and store in cool and dark place till use. Seeds should be sown as soon as possible. |
| SEED PELLETING : BIO-ZINC coated seeds are sprinkled with powdered neem cake or neem leaf powder and mix with hands before sowing. Seeds can also be coated with 2-3% of calcium carbonate if soils are acidic in nature |
| SOIL APPLICATION :Use 500ml BIO-ZINC dilute with 100 lit of water. Spread this emulsion evenly in the elds |
| SOIL BROADCASTING :Mix 500 ml BIO-ZINC with 50kg of cow dung. Add water to make the mixture damp and cover it with a porous gunny bag. Mixing should be done in shade. After 12 hours broadcast the mixture over 1 acre [0.4 ha] |
| CAN BE USED WITH DRIP IRRIGATION TOO. |
Rice, Sugarcane, Millets, Coconut, Cotton, Banana, Cardamom, Coffee, Rubber, Tea, Vanilla and all Agricultural and Horticultural crops.
packing : 100ml/ 500ml / 1000ml